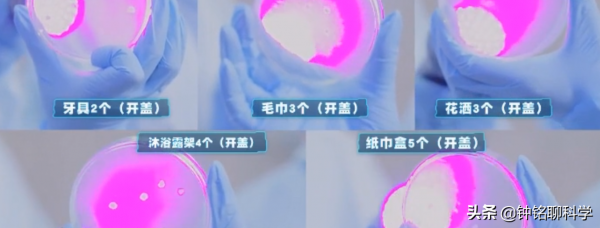
衝馬桶一定要蓋馬桶蓋！實驗告訴你，衝馬桶不蓋馬桶蓋風險有多大
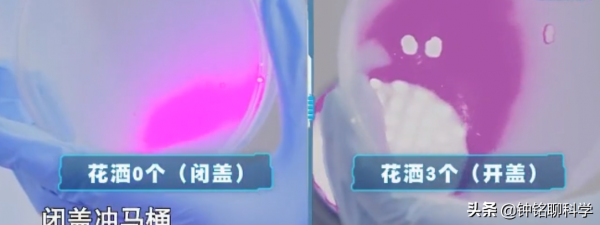
衝馬桶一定要蓋馬桶蓋！實驗告訴你，衝馬桶不蓋馬桶蓋風險有多大

衝馬桶時,你會蓋上馬桶蓋再衝,還是敞開式直接衝?或許看完這篇文章,會讓你有新的改觀。
人類的糞便之中,除了有食物殘渣,脫落的細胞之外,還有許多細菌、病毒甚至是寄生蟲等生物,它們身影非常小,肉眼無法看到,但它們卻可能會在我們衝馬桶時,而飄落到衛生間的角落之中。
有人曾經利用乾冰做過一次衝馬桶實驗,乾冰的氣體密度比空氣大,所以一般情況下,乾冰所產生的煙霧應該會在底層空間。
工作人員利用乾冰模擬馬桶內的微生物們,然後敞開馬桶蓋沖水,結果馬桶蓋沖水時產生的氣流帶動了乾冰煙霧向上飄散,其中越是靠近馬桶口,乾冰煙霧越濃,這也說明身高越矮,受到的影響越大。
其中在衝馬桶過程中,馬桶水流會將一部分水汽混合著糞便顆粒或者是尿液被衝入到了馬桶上方,以氣溶膠的形式停留在空中。
2014年時,有人利用紫外線顯色顏料,與高速攝像機,將開著馬桶蓋沖水的一瞬間拍攝了下來。
結果發現,馬桶內的汙染物竟然可以噴濺到約60釐米之外的地面上;從馬桶中飛出來的微小水滴,也可以噴射到了約1.8米外的牙刷上。
央視節目《加油向未來》中,也做過一次蓋馬桶蓋和不蓋馬桶蓋的實驗,為了保證實驗的嚴謹性,兩名工作人員身穿無菌服,處於無菌的房間內,然後將一種添加了熒游標記的細菌倒入到馬桶內,然後在馬桶周圍的物體上,放了5個細菌培養皿。
首先是模擬的不蓋馬桶蓋的後果,結果顯示在不蓋馬桶蓋的實驗中,所有的培養皿中都出現了標記細菌,而且數量還不少。
第二次模擬的是蓋馬桶蓋的後果,結果顯示蓋上馬桶蓋之後,雖然也有細菌濺出,但數量明顯要少,而且有許多培養皿中都沒有發現細菌。
透過以上實驗,可以看出蓋上馬桶蓋,可以有效減少細菌濺出的風險。
除此之外,馬桶的不同也會影響要不要蓋馬桶蓋,如果你家所使用的是虹吸式馬桶,那麼蓋不蓋馬桶蓋的印象並不大。
不蓋馬桶蓋會傳播疾病嗎?
既然不蓋馬桶蓋會讓馬桶內的汙染物濺出,而馬桶內的汙染物中,又有許多是細菌、病毒等微生物,那長期處於這樣的環境之下,人類會生病嗎?
其實,不蓋馬桶蓋雖然會噴出較多的汙染物,但並不一定會引起人們生命。
首先是因為微生物種類數量眾多,但是大多數微生物對人類無害,只有極少數微生物能夠感染人類,造成人類患病。
其次,即便是致病菌,或者是人類易感病毒,也要達到一定的數量才能夠感染人類,少量的病毒或者細菌進入人體後,將會被人體的免疫細胞清理出去,從而保證了人類的健康。
還有,致病菌或者致病病毒想要感染人類,還要取決於人類的抵抗能力。如果人類對一些病毒具有抵抗能力,比如:注射了HPV疫苗的人,對HPV病毒具有一定的抵抗能力,即使接觸也不一定會感染。
更為重要的是,定期開窗通風也能夠有效改善衛生間內的空氣質量,如果是沒有窗戶的衛生間,那麼使用通風系統也能取得類似的效果。
總結
即便是衝馬桶時蓋上馬桶蓋,經常開窗通風,也要經常清理馬桶周圍的空間,因為衛生間比較溫暖潮溼,犄角旮旯處又較多,很容易滋生細菌。經常清理馬桶周圍有利於保持衛生間的衛生環境。